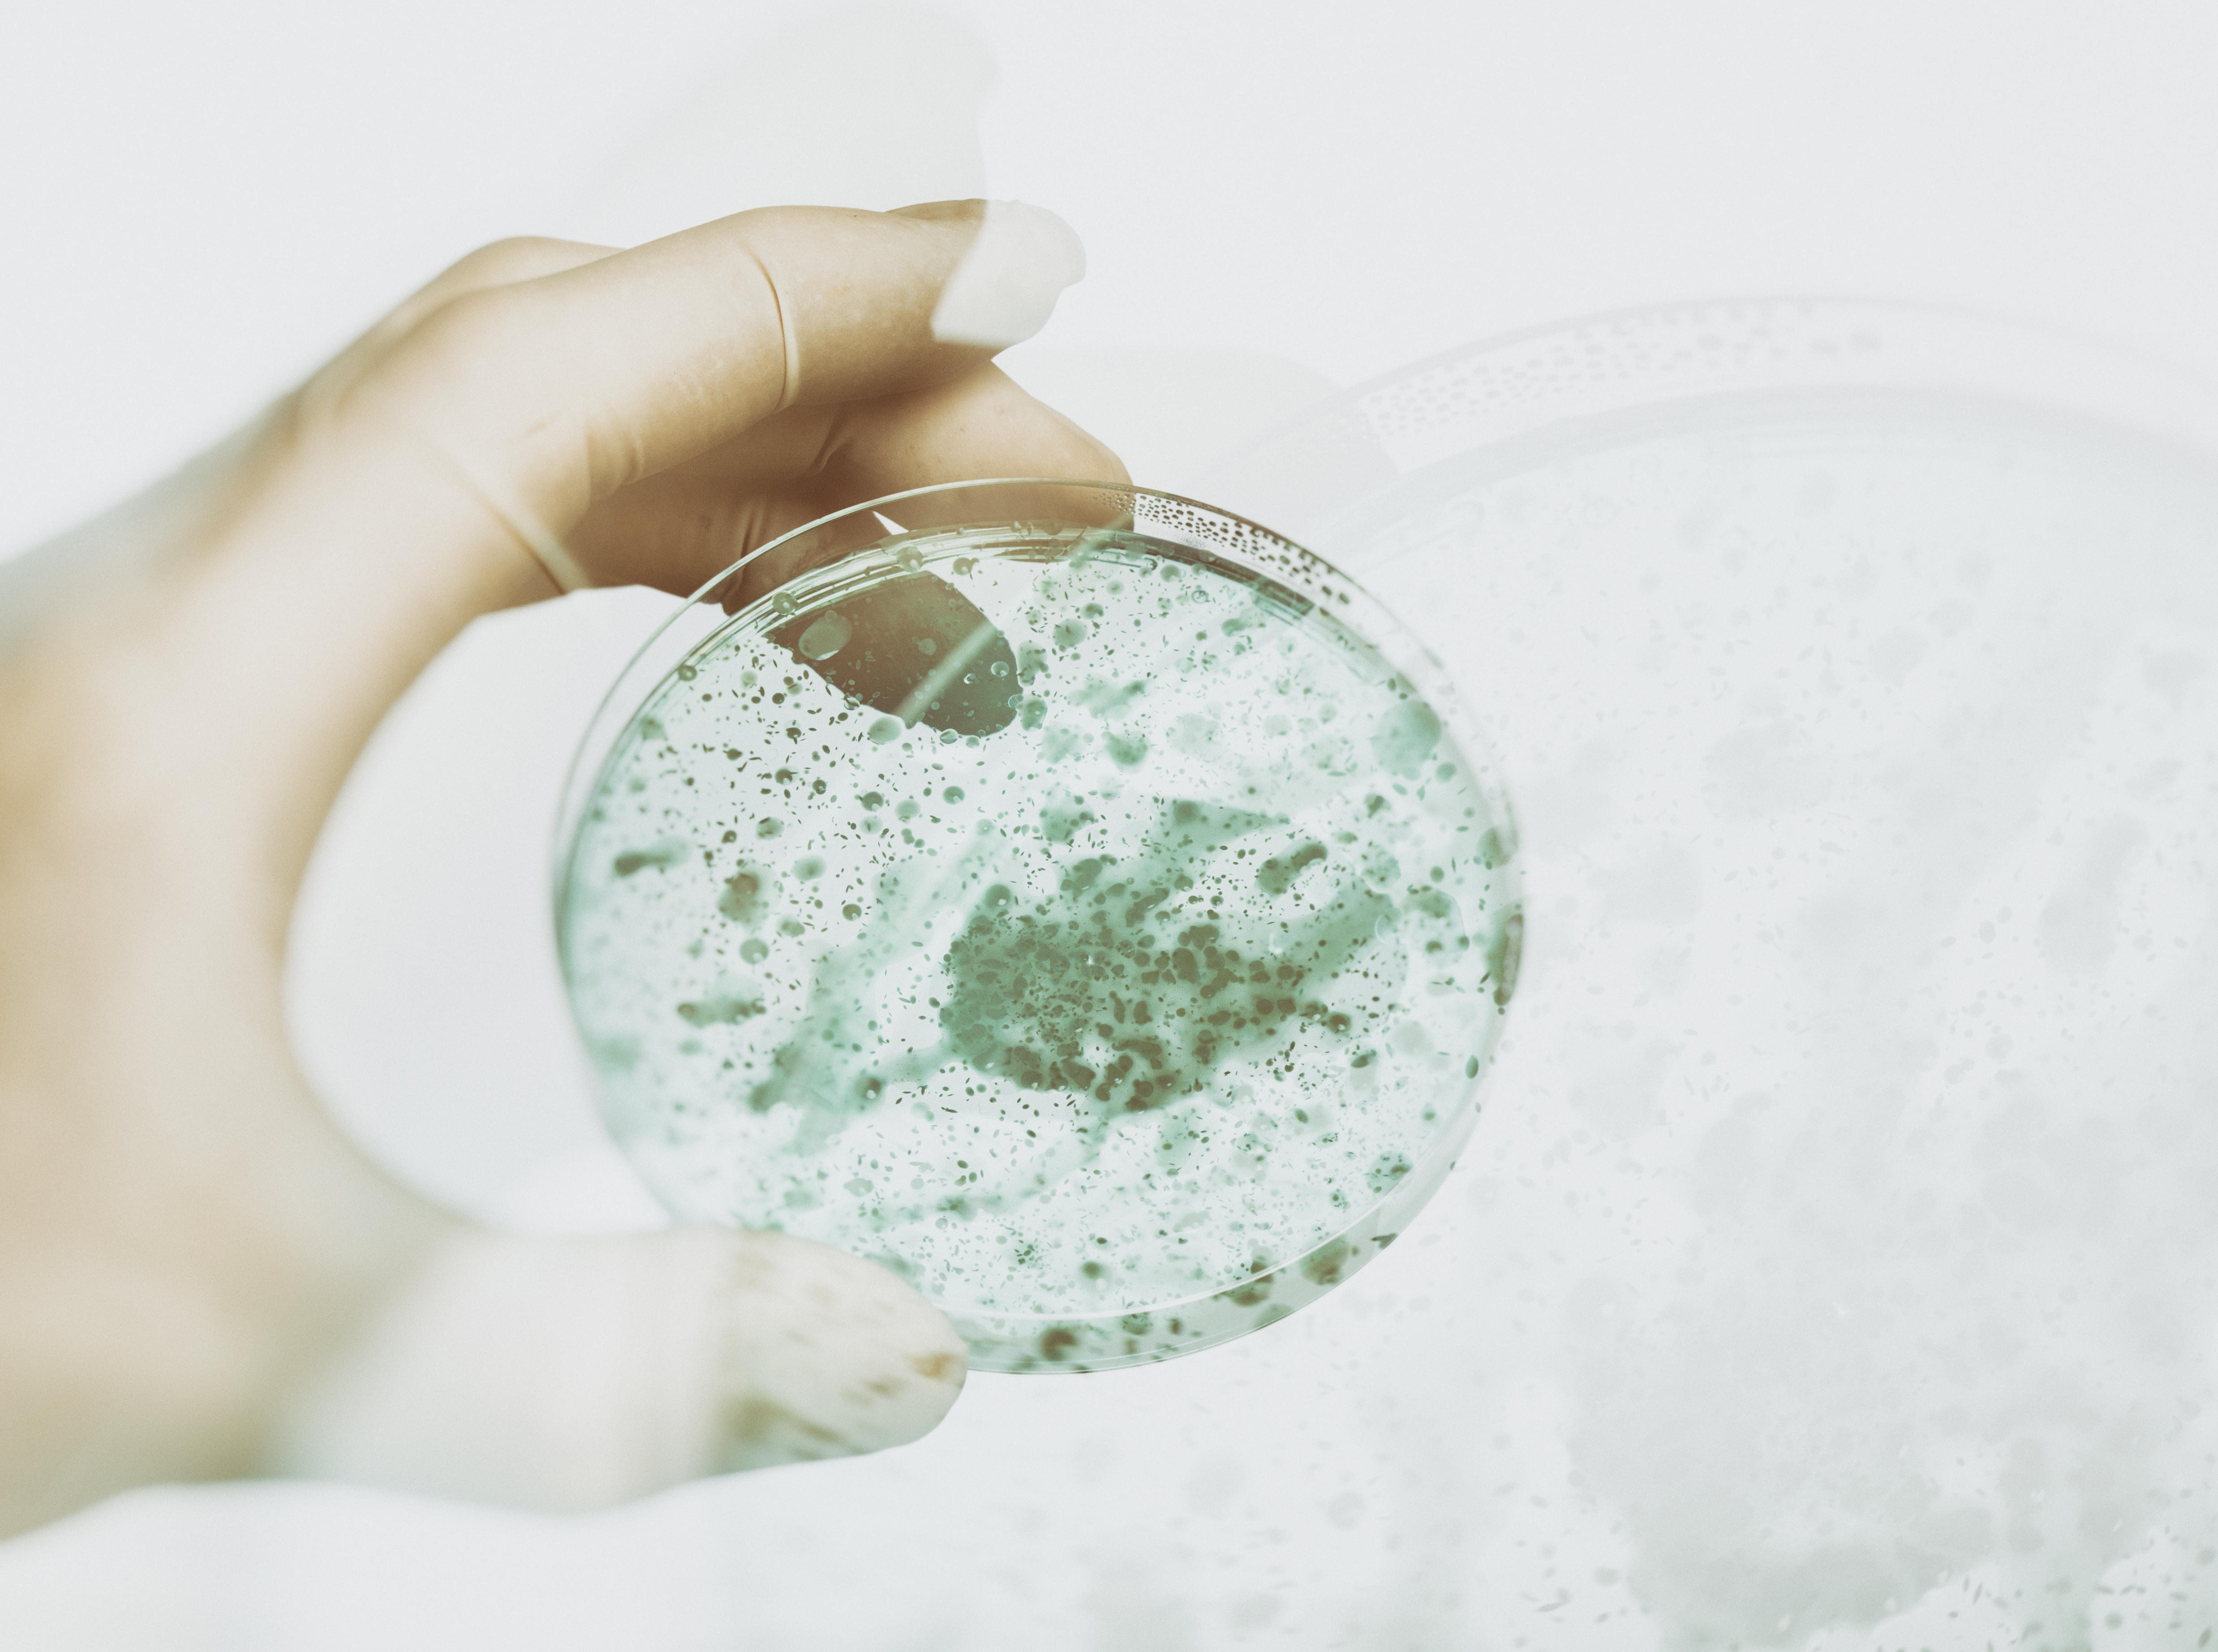

bulletin boardmailEvents that will change history.
January 1, 2025
— contents —
~ letter
~ watching
~ reading
— letter —
Dear Ray,
Your talks inspired an idea I have — ranking the most significant upcoming events in history — that could happen within the next 1 to 5 decades. Human civilization is on the brink of incredible breakthroughs.
Some examples.
- becoming multi-planetary through space travel
- curing old age + all disease with genetic engineering or nano-medicine
- inventing computer super-intelligence that can think like a human
- creating artificial intelligence that uses language like a human
- inventing a direct method to transfer thoughts from person-to-person / person-to-device / device-to-person
digital life
- virtual reality + augmented reality
- crypto-currency + block-chain apps
- quantum computing
- 3D printing
- AI doing things better than people —like self-driving cars, medical radiology, legal research, fraud detection
- AI doing things people can’t —like processing huge quantities of data quickly
global progress
- life extension
- urban vertical farming
- new energy solutions with nuclear + solar
- new types of batteries
- exploring super-materials like graphene
- all people getting access to web, energy, education, and health-care
exploration + travel
- putting humans on planet Mars
- building a sustainable human base on the moon
- fast overseas travel — space rockets by Space X
- fast continental travel — underground HyperLoop by SpaceX
The 2020s will be amazing.
— Ryan


— letter —
Dear Ryan,
Thanks for your good list. I appreciate your reporting on upcoming discoveries and new capabilities — these will definitely change our planet + civilization.
Wishing you a productive, exciting, and positive decade ahead — as humanity takes its first steps into this new era.
— Ray Kurzweil
IMAGE
watching
1. |
publication: INSH
tag line: Obscure and not so well-known stories from history, geography, science, and culture.
web: home
series: What If
tag line: An epic exploration of possibilities.
web: home ~ channel
featurette title: What if you lived 50 years in the future?
watch | featurette
— about —
It feels like the world is moving at a faster rate than ever. Every day, smart-phones are getting smarter, AI is becoming more intelligent, and our environment seems to be getting worse every year. If you could travel 50 years into the the future, what would the world look like?
presented by
group: Underknown
tag line: Asking questions is our craft.
web: home
2. |
publication: the B1M
tag line: The definitive video channel for construction.
motto: We live construction, and we want the whole world to love it too.
web: home ~ channel
featurette title: HyperLoop explained
watch | featurette
featurette title: 10 HyperLoops that will change the world
watch | featurette
featurette title: building the first HyperLoop passenger capsule
watch | featurette
IMAGE
reading
publication: Forbes
tag line: Change the world.
web: home ~ channel
1. |
story title: These are the technologies that will transform the 2020s
read | story
— about —
From 5g to vertical farming. Shared mobility, advanced plastic recycling, and protein production are also going to be key to future prosperity.
2. |
story title: Energy ‘s Future: battery + storage tech
read | story
— about —
Lifting our power generation + electrical grid into the 21st century is a multi-pronged effort. It needs a new generation mix of low-carbon sources that include hydro, renewables, and nuclear — plus ways to capture carbon that don’t cost zillions of dollars, and ways to make the grid smart.
presented by
group: Integrated Whale Media Investments
reading
3. |
publication: Vox
tag line: Understand the news.
web: home ~ channel
story title: Why home 3D printing never lived up to the hype
read | story
— about —
Enthusiasts imagined a future where ubiquitous 3D printing rendered a lot of conventional manufacturing obsolete — as people printed everything from dishes to automobile parts at home, instead of buying them in a store or on the web. But the home 3D printing revolution hasn’t panned-out. Here’s why.
presented by
group: Vox Media
tag line: Dedicated to getting the future right.
web: home ~ channel
4. |
publication: the Verge
tag line: We examine how tech will change life in the future.
web: home channel
story title: This decade in Elon
read | story
— about —
SpaceX, Tesla, Neuralink, the Boring Company — and of course that Twitter account.
presented by
group: Vox Media
tag line: Dedicated to getting the future right.
web: home • channel
5. |
publication: the Verge
tag line: We examine how tech will change life in the future.
web: home • channel
story title: Elon Musk proposes city-to-city travel by rocket — right here on Earth
read | story
— about —
Anywhere on Earth in under and hour: Musk says.
presented by
group: Vox Media
tag line: Dedicated to getting the future right.
web: home • channel
6. |
publication: Cosmos
tag line: The science of everything.
web: home • channel
story title: The HyperLoop alternative to a very fast train
read | story
— about —
A cheaper, swifter means of mass transit by land is on the horizon.
presented by
group: the Royal Institution of Australia
tag line: Bringing science to people, and people to science.
web: home • channel
7. |
publication: GigaOm
tag line: Leading global voice on emerging tech research + analysis.
web: home • channel
story title: What is graphene?
read | story
— about —
Here’s what you need to know about a material that could be the next silicon. Graphene is made of a single layer of carbon atoms, bonded together in a repeating pattern of hexagons. It’s 1 million times thinner than paper — so thin it’s actually considered 2-dimensional. Carbon is an incredibly versatile element.
presented by
group: Knowlingly
tag line: ~
web: home channel
IMAGE
— notes—
2D = 2-dimenional
3D = 3-dimensional
AI = artificial intelligence
VR + AR = virtual reality + augmented reality